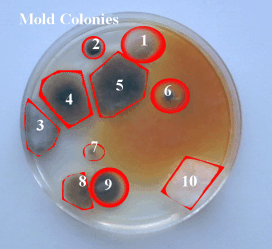

- Is there a musty smell in the building?
- Are there visible signs of water damage anywhere?
- Has the building ever suffered a leaking basement?
- Has the building ever suffered a roof leak?
- Has the building ever suffered a plumbing leak?
- Has the building ever suffered a sink or sewer overflow?

- Skin Rashes
- Fatigue
- Depression
- Unexplained Irritability
- Flu-like Symptoms
- Trouble Breathing
- Coughing
- Sinus Congestion
- Nausea
- Sneezing
- Runny Nose
- Loss of Memory
- Loss of Hearing
- Loss of Eyesight
- Bloody Noses
- Arthritic-like Aches
- Chronic Headaches
- "Crawly" Feeling Skin
- Epileptic-like Seizures
- Upper Respiratory Distress
- Irritation of the eyes, nose or throat
- Restlessness
- Equilibrium or Balance Loss
- Dizziness or Stuffiness


Environmental Protection Agency (EPA) studies of human exposure to air pollutants indicate that indoor air levels of many pollutants may be two to five times higher than outdoor levels. These levels of indoor air pollutants are of concern because it is estimated that most people spend as much as 90 percent of their time indoors.
Stachybotrys Chartarum (Toxic Black Mold) is a greenish-black fungus found worldwide. It colonizes in most building materials including concrete, dry wall, carpeting, wall paper, fiber board, ceiling tiles, and thermal insulation.
The fungus can be wet and slimy to the touch. There are about 15 species of Stachybotrys world-wide. This toxic mold grows in any area that experiences a period of high moisture.
Molds produce allergens that can trigger allergic reactions & asthma attacks in people allergic to mold. Other molds are known to produce potent toxins and/or irritants. Potential health concerns are an important reasons to prevent any existing indoor mold growth.
Some molds are cryophytes (these adapt to low temperatures), some are thermo tolerant (they adapt to a wide range of temperatures) and some are thermophiles (they adapt to high temperatures). Depending on the species, these little organisms will grow just about anywhere. Mold requires a compatible temperature for each species. Since the thrust of this current site is indoor mold, the environmental factors (temperature, nitrogen, oxygen, etc.) are necessary grounds for mold to thrive.

Mold also needs an organic source of food. People might be confused as mold can grow on glass, tile, stainless steel, cookware, etc. but it is generally feeding off of some organic source deposited on this material (oils, films, dirt, skin cells, etc.). The fiberglass insulation people like to say that mold does not grow on their product which is a fairly true statement, however, it grows on the organic debris that become trapped in their products . Mold also grows on things such as wood, fabric, leather, gypsum, fiberboard, drywall, stucco, and many insulation fibrous materials. All molds do require some form of moisture to grow, however, like temperature, the amount of moisture varies for different species. Some are xerophillic (colonize under very dry conditions) some are xerotolerant (colonize under a wide range of moisture levels) and some are hydrophilic (colonize at high moisture levels). It doesn't have to be a leak.. . . Humidity or moisture content of the substrate can often be sufficient (relative humidity over 50% start becoming problematic in many indoor cases.) It can spread very easily through any HVAC system. Mold will start growing any time water is present. Many structures of which have flat roofs that collect water, are notorious for leaks. Chronic leaks can turn ceiling tiles, wallboard or wood into ready-to-eat mold food.
WHAT IS MOLD?
Molds are microscopic organisms found virtually everywhere, indoors and outdoors. Mold spores are tiny, lightweight, and easily detached by airflow, vacuuming, walking on a carpet or sitting on a couch. In indoor environments, they grow in air-conditioning ducts, carpets, pots of household plants, etc. They produce and release millions of spores, which are small enough to stay airborne threatening to invade the human respiratory system. Mold growths can often be seen in the form of discoloration, ranging from white to orange and from green to brown and black. In large quantities, molds can cause allergic symptoms similar to those caused by plant pollen. In order for mold to grow, it needs food sources (such as leaves, wood, paper, or dirt), a source of moisture, and a place to grow.


UNDERSTANDING TYPES OF MOLD
Allergenic molds are normally not dangerous in low amounts, but they can cause allergenic or asthmatic symptoms such as wheezing or runny nose. These molds can be abated safely with the assistance of gloves and a disposable particulate-removing respirator.
Mycotoxic molds can cause serious health effects in humans and animals. Health effects range from short-term irration to immunosuppression to cancer and even death. If any toxic molds are identified, it is suggested that you seek advise from an mold professional for guidance. The average homeowner should NOT attempt the abatement of these types of mold.
Pathogenic molds can cause serious health effects in persons with with suppressed immune systems, those taking chemotherapy, those with HIV/AIDS, or autoimmunity disorders. If any pathogenic molds are identified, it is suggested that you seek advise from a mold professional for guidance. The average homeowner should NOT attempt the abatement of these types of mold. Hyphae & hyphal elements refer to single, unidentifiable fragments of mold. Although they may not be traceable to a specific mold species, the fragments themselves may be responsible for allergic reactions in some people and may indicate pervious or current growth event. Smut spores are agricultural spores from outside sources. Ascospores and basidiospores are clusters of spores that may not be easily identified as per specific species, but may still represent a mold problem in the home.
HOW DO YOU COME INTO CONTACT WITH MOLD?
Mold spores are found in all homes and offices, and grow rapidly from excess Humidity. The following are some sources of indoor moisture that may cause mold problems in a home or office: flooding, leaky roofs, humidifiers, damp basements or crawl spaces, constant plumbing leaks, house plants, steam from cooking, shower/bath steam and leaks, wet cloths, bathroom towels, pets, sweaty sneakers indoors, dirty HVAC systems, spilled liquids on carpeted surfaces and clothes dryers vented indoors.
WHAT CAN MOLD DO TO YOU?
Exposure to mold is not healthy for anyone but the following individuals are at a higher risk for adverse health effects: infants, children, elderly, immune compromised patients, pregnant women, and individuals with existing respiratory conditions. When inhaled, even in small amounts, mold can cause a wide range of health problems including respiratory problems (wheezing), nasal and sinus congestion, watery and red eyes, nose and throat irration, aches and pains, fevers, and in some cases even death.
CAUSES OF INDOOR MOLD GROWTH
High moisture is the major contributor to indoor microbiological activity (mold growth). This is due to nutrients for spore germination and growth being readily available in most household constituents. These houshold constituents can be dirt, dust, wood, paper, adhesives, acoustical fiber, paint textiles, stored material, carpets, floors, and much more. The actual germination of fungal spores and mold growth is influenced by several factors. These factors ar as follows: Time Reaming Wet: The longer the materials stay wet, the higher probability of mold growth. Water Source Contamination: The greater the water sources, the greater the microbiological activity. (Ex. Loose toilet, pipe condensation, pipe leaks, foundation leaks, crawl space leaks, ice dams, and etc.) Substrate: Fungi prefer natural materials. Some fungi will grow on almost anything. Light: Most molds thrive in dark places. (Ex. closets, attics, basements, inside walls, behind wallpaper, behind refrigerators.) Temperature: Temperatures between 68°F and 86°F are the optimal temperatures for microbiological activity. Air Velocity: Microbiological activity is preferred in stagnant areas. This is why you see more molds in closets, attics and inside walls. Nutrients: Organic material such as drywall, wood, ceilings, adhesives, paper, plasters, leather, and cloth ar ideal for growth. (Ex. no desirably clean homes have more dust and debris than that of clean homes and will most certainly produce more microbiological growth.) Humidity: Anything above 50% RH (relative humidity) is desirable for mold growth. Moisture: When substrates are wet or damp the opportunity for microbiological activity is great. Mositure content 18% or greater can cause mold growth. (Ex. Basement drywall, basement wood paneling, drop ceiling material after it gets wet, cardboard boxes on the basement floor etc.)


WARNING SIGNS OF POSSIBLE MOLD GROWTH
Tree Roots have been known to infitrate into storm and sanitary lines. When these conditions arise, sewer back up and basement wall moisture are usually the outcome. Tree roots also have a tendency to damage pavments and foundations, which could lead to moisture in basements. We strongly urge you to question the past owner if the past seepage or sewer backup has existed, if it has, future maintenance will be probable, and biohazards may exist. Moss, mold or mildew on the foundation or on the foundation grading is an indication of poor grading, shading, overflowing gutters, runoff, or other conditions that allows this area to be wet, moist, or humid. Roofs are hazardous and dangerous to phsyically walk on. Your inspection should be only based on what is visible from the ground level with or without binoculars. A roof may show evidence of past pr present leaks or may soon develop leaks that can cause mold growth. The condition of a flat, metal, or built up roof often cannot be determined unless it is possible for you to closely inspect its surface. Poor roof venting and sometimes tree shading can decrease the overall life expectancy of the roofing system and cause mold growt. Shingles that are uplifting or have popping nails are indicators of potentially undesirable attic moisture conditions. Shingles that are clawing or fish mouthing are indicators of poor attic ventilation. Efflorescence (white powdery substance) and staining of the chimney is an indication of moisture penetrating the system. Chimney Flashing, roof penetrations, other flashing, changes in roof elevation, all have the potential of future maintenance when downspouts and gutters are not properly maintained on garages and dwellings, poor drainage can cause seeping into the dwelling. All gutters and downspouts should be free of debris and properly installed. Many time, past property owners disconnected downspouts at the base and install splash type blocks. These types of repairs may be indicators of past seepage, which the present owner should disclos. Penetrations at vents, Chimenys, and roof flashing should be inspected periodically for deterioration and possible leaks. Overflowing gutters, downspouts, and leaking roofs can cause mold growth. Exterior Wood Surfaces should be treated every 3-5 years. When wood is untreated, it has the potential to develop mold growth that will cause deterioration or possibly enter the dwelling. Untreated wood used for porches, deck columns, and fence posts which are buried in the ground, have a tendency to deteriorate rapidly from mold. Siding should be properly sealed and should have existing weep holes. Foundations that have cracks or problems can cause moisture seepage into dwellings. Drywall nails pops or rusted drywall nails may be the cause of high indoor humidity or possible past/present leaks that may cause mold to grow on exposed or not exposed surfaces. These types of conditions should be controlled. Many times homeowners patch and paint past ceiling or wall leaks. At these locations, we cannot tell if future seepage is expected, unless, it is actually wet or leaking at the time of inspection. Mold is often in walls behind drywall or behind wallpaper. Cleaning carpets often cause high humidity in homes leading to mold growth under the carpet. Attic Temperature that is greater then 30 degrees from exterior ambient temperature should have venting or an attic fan installed. When mold/mildew or dark staining is seen in accessible locations, on or in the sheathing, deterioration may exist. These conditions may be the cause of: condensation during winter months, ice dams, poorly vented bathrooms or kitchen vents, poor attic venting, insulation choking air flow, roof or penetration seepage, and repairs are advised. Most attics are only partially inspected due to constraints such as height, tigh, claustrophobic conditions, missing flooring, area cluttered, covered, and difficult entry. At the time of inspectio, you only inspect a small sample of strutural members and a small sample of sheathing. Attic moisture stains should be monitored for future activity and repaired if active, so further damage or mold growth will not occur. Moisture stains may appear to be dry at the time of inspection, due to; dry weather conditions, hot summer heat, and winter months. Disclosures: Ask if any past seepage of flooding existed from: sewers, storms, and run-off. Basements and crawl spaces have a high probability of containing humid conditions that are desirable for mold growth. Wood products, cellulose products, boxes, paneling, and drywall are not recommended in basements that do not have controlled moisture and humidity. Generally, if you see black mold on the bottom of cardboard boxes you may have a serious mold condition. A high probability exists that mold may be behind drywall or wood paneling if a basement is not 100% dry. Any wood paneling, drywall, or ceiling tiles that are contact with water, high moisture, flooding, or seepage should be removed within 24 hours after getting wet. Furthermore, we recommend you remove at least an additional 12 inches of material past and away from the moisture stains or water-damaged area. Humidifiers on furnaces if not properly used will cause condensation on sheathing in the attic. The condensation will result in a black mold appearance. Mold growth on attic sheathing is not desirable and not heathly if mold spores from the attic enter the dwelling. We recommend to seal off attics with these conditions and call professionals to help in the remediation or interim control progress. Leaking basements and leaking crawl spaces can also cause this black mold in attic sheathing, other high humidity causing variables that exist in the dwelling. Humidifiers, furthermore, are known to contain microbiological growthwithin their operating housing. We recommend these areas be properly cleaned periodically. Ductwork in dwelling has a high probability to contain dust, debris and possible microbiological growth. We recommend to have all ductwork professionally cleaned. Many older homes have return air ducts not connected to heating systems, return air generally must come from the crawl space or basement. Generally, basement or crawl locations can be wet, moist, musty, moldy, etc. We recommend to connect the cold air returns to the furnace. The furnace filters need to be cleaned or replaced periodically according to the manufacturer specifications. We recommend to install HEPA or high-density filters to help in the control of filtering out microbiological airborne particles, dust, etc. The company does not accept any responsibility for financial or health consequences of substantial action taken by the client or its consultants based on this report or test results.
Gateway can provide you with a thorough home inspection and/or an in depth physical inspection of your home or other real estate to find signs or evidence of water and mold damage, plus do comprehensive mold testing and mold investigation utilizing every type of mold testing technology, plus hidden moisture meter (to find water hidden inside walls, ceilings, and floors), fiber optics inspection device (to find mold hidden inside walls, ceilings, and floors), and a hygrometer (to check your home for elevated levels of mold-causing humidity). Moisture meter and inspection fiber optic devices will tell if there is moisture in walls, ceiling, floors. If it is wet, mold will grow 24-48 hours. Gateway will find these wet spots.
$750.00 Gateway can provide a visual inspection of Moisture, moisture meter testing and humidity. This is not a physical inspection but can give you an idea if there is water coming into the house do to drainage around property. Plumbing leaks. Signs of water in walls detected with meter. Roof or siding leaks. Check for proper crawlspace and attic and ventilation. 2 air quality samples will be taken in the most suspected rooms with Air-O-Cell. 10 Petri dishes will be set in various rooms and be spore counted by lab. If there is moisture this is usually enough to determine if there is mold growth. You can decide if you would like to have mold samples taken. Highly recommended if there is moisture, Humidity, or visual signs of mold. This is our best deal. This is minimum testing but can give you an idea of how much mold growth or air born spores is in your home without spending alot of money.

